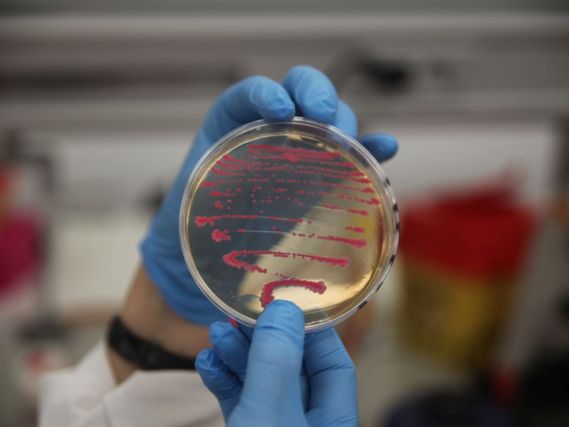

Les étudiants du Master en génie de l’environnement, enseigné par l’Université européenne de l’Atlantique (UNEATLANTICO), ont participé à des journées en personne axées sur l’étude théorique et pratique des facteurs environnementaux du sol et de l’eau.
La première journée a commencé par une conférence donnée par le Dr. José Ramos Vivas, qui a abordé des thèmes liés à la microbiologie appliquée aux sols, depuis les cultures jusqu’à la bioremédiation. Cette session a été complétée par un stage en laboratoire, où les étudiantes ont eu l’occasion de réaliser différentes analyses avec des échantillons de microbiote dans les sols et les sources d’eau.
Au cours de la deuxième journée, les résultats ont été analysés et des conclusions ont été tirées dans le laboratoire sur les pratiques effectuées la veille. À cet égard, les étudiantes du Master ont soulevé différentes questions sur la façon dont la biorésolution peut améliorer la qualité des sols et restaurer un site pollué.
Le Master en génie de l’environnement, est conçu comme un programme d’études supérieures spécialisé qui forme des professionnels capables de faire face aux défis environnementaux et de promouvoir les bonnes pratiques durables, en particulier dans les environnements industriels. Sa méthodologie de formation, qui combine théorie et pratique, permet aux étudiants d’acquérir à la fois des connaissances fondamentales et des compétences avancées, en les rapprochant des besoins réels de la société et en encourageant leur intérêt scientifique et leur vocation de recherche.